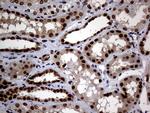
MGMT Antibody in Immunohistochemistry (Paraffin) (IHC (P))

Search
OriGene
MGMT Monoclonal Antibody (OTI6G6), TrueMAB™
{{$productOrderCtrl.translations['antibody.pdp.commerceCard.promotion.promotions']}}
{{$productOrderCtrl.translations['antibody.pdp.commerceCard.promotion.viewpromo']}}
{{$productOrderCtrl.translations['antibody.pdp.commerceCard.promotion.promocode']}}: {{promo.promoCode}} {{promo.promoTitle}} {{promo.promoDescription}}. {{$productOrderCtrl.translations['antibody.pdp.commerceCard.promotion.learnmore']}}
产品信息
CF809195
种属反应
宿主/亚型
分类
类型
克隆号
抗原
偶联物
形式
浓度
纯化类型
保存液
内含物
保存条件
运输条件
产品详细信息
For reconstitution, we recommend adding 100 µL distilled water to a final antibody concentration of about 1 mg/mL. To use this carrier-free antibody for conjugation experiments, we strongly recommend performing another round of desalting. (Zeba Spin Desalting Columns, 7KMWCO, 0.5 mL, Product # 89882)
靶标信息
O6-Methylguanine-DNA Methyltransferase (MGMT) is an important DNA repair protein involved in tumor cell resistance to the cytostatic activity of chemotherapeutic alkylating agents. This protein is also effective in protecting normal cells against the genotoxic and carcinogenic effects of DNA alkylation. The alkylating drug resistance is caused by MGMT's ability to remove DNA alkyl groups introduced in the O6 position of guanine. MGMT is expressed in highly variable amounts, depending upon the cell and tissue type, species, and cellular growth characteristics. In addition, MGMT activity varies among groups of tumors and within a particular type of tumor.
仅用于科研。不用于诊断过程。未经明确授权不得转售。
篇参考文献 (0)
生物信息学
蛋白别名: 6-O-methylguanine-DNA methyltransferase; methylated DNA protein cysteine methyltransferase; Methylated-DNA--protein-cysteine methyltransferase; methylguanine-DNA methyltransferase; MGMT; O-6-methylguan; O-6-methylguanine-DNA-alkyltransferase; O6-methylguanine-DNA methyltransferase
基因别名: MGMT
UniProt ID: (Human) P16455
Entrez Gene ID: (Human) 4255